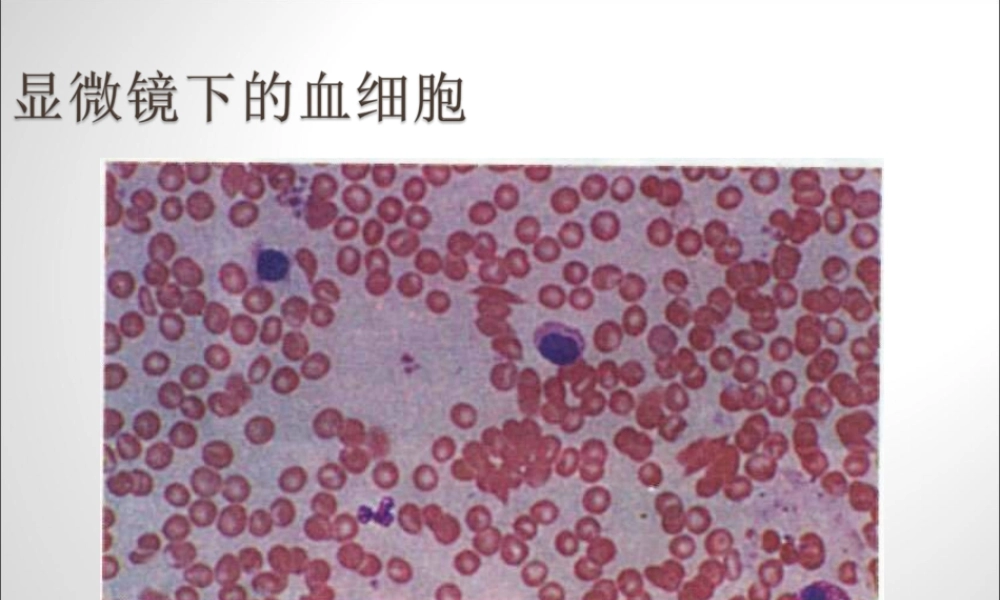
练习使用显微镜公开课原创

埃博拉病毒(英语: Ebola virus )是丝状病毒科中的一种病毒
2014 年 2 月爆发于西非到目前为止已有 2800 人死亡,研究表明埃博拉病毒死亡率达 70%
最早的显微镜是由一位荷兰眼镜商在 1600 年前后制造的,它的结构简单,放大倍数不高,只有 10 ~ 30 倍,可以观察一些小昆虫,如跳蚤等
半个多世纪后,英国物理学家罗伯特 · 虎克( Robert Hooke , 1635—1703 )研制出能够放大140 倍的光学显微镜,并用它来观察软木薄片,发现了细胞
哪些部件可以将观察材料放大
1 、显微镜的结构有什么用
2 、怎样使用显微镜
3 、操作过程有哪些注意事项
问:观察什么应借助显微镜
答:微小的物体和细胞
目的:1 、练习使用光学显微镜
2 、学习规范的操作方法
光学显微镜写有“上”字的塑料片动物或植物玻片标本完成以下任务
一、取镜和安放
1 、这个步骤里面要注意什么
注意不能摔坏显微镜,不要触摸镜片等等光学显微镜介绍如何对光
看到明亮视野表示对光成功
这个步骤要注意什么
不要用手扳物镜,用低倍物镜、用较大光圈、对光完不要移动、光线强用平面镜,光线弱用凹面镜等等
首先用肉眼观察一下人血涂片
看到了什么
1 、练习将所观察的物像移动到视野中央
和肉眼看到的有什么区别
然后在放在显微镜下观察
2 、移动标本的时候,物象是怎么样移动的
相反方向5 、观察的时候注意什么
如:标本放在通光孔中央,下降镜筒时,眼睛要注视物镜,不移动显微镜
3 、你看到的“上”字塑料片,的物像是怎样的
4 、拿尺子观察一个数字,如 2
5 、观察的时候注意什么
如:标本放在通光孔中央,下降镜筒时,眼睛要注视物镜,不移动显微镜
四、实验完毕,要干什么
整理好显微镜
有需要可以用擦镜纸擦镜头
学习总结 1 、显微